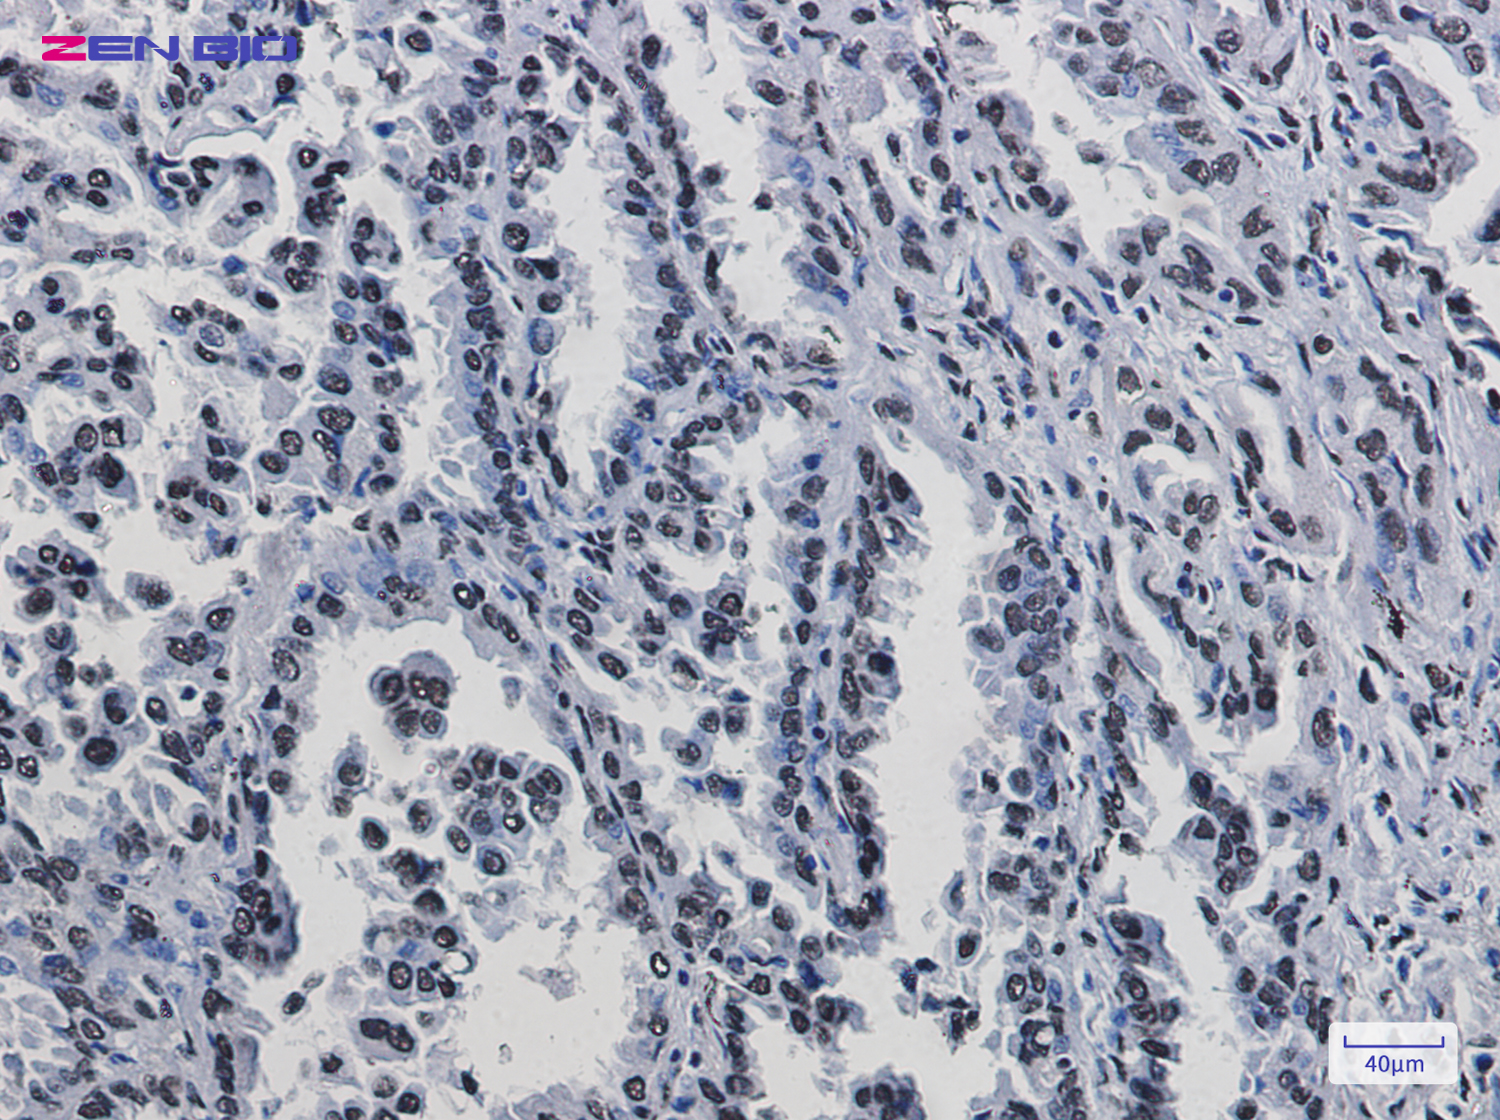
Immunohistochemistry of KAP1 in paraffin-embedded Human lung cancer tissue using KAP1 Rabbit pAb at dilution 1/50

-
Product Name
Anti-KAP1 Rabbit antibody
- Documents
-
Description
KAP1 Rabbit polyclonal antibody
-
Tested applications
WB, IHC-P, ICC/IF
-
Species reactivity
Human, Mouse, Rat
-
Alternative names
KAP1; TF1B; RNF96; TIF1B; PPP1R157 antibody
-
Isotype
Rabbit IgG
-
Preparation
Antigen: A synthetic peptide of human KAP1
-
Clonality
Polyclonal
-
Formulation
Supplied in 50nM Tris-Glycine(pH 7.4), 0.15M Nacl, 40%Glycerol, 0.01% sodium azide and 0.05% BSA.
-
Storage instructions
Store at -20°C. Stable for 12 months from date of receipt.
-
Applications
WB: 1/1000
IHC: 1/50
ICC/IF: 1/50
-
Validations
Immunohistochemistry of KAP1 in paraffin-embedded Human lung cancer tissue using KAP1 Rabbit pAb at dilution 1/50

Immunocytochemistry of KAP1(green) in Hela cells using KAP1 Rabbit pAb at dilution 1/50, and DAPI(blue)

Western blot detection of KAP1 in K562,C6,3T3,Hela cell lysates using KAP1 Rabbit pAb(1:1000 diluted).Predicted band size:89kDa.Observed band size:100kDa.
-
Background
Swiss-Prot Acc.Q13263.Nuclear corepressor for KRAB domain-containing zinc finger proteins (KRAB-ZFPs). Mediates gene silencing by recruiting CHD3, a subunit of the nucleosome remodeling and deacetylation (NuRD) complex, and SETDB1 (which specifically methylates histone H3 at 'Lys-9' (H3K9me)) to the promoter regions of KRAB target genes. Enhances transcriptional repression by coordinating the increase in H3K9me, the decrease in histone H3 'Lys-9 and 'Lys-14' acetylation (H3K9ac and H3K14ac, respectively) and the disposition of HP1 proteins to silence gene expression. Recruitment of SETDB1 induces heterochromatinization. May play a role as a coactivator for CEBPB and NR3C1 in the transcriptional activation of ORM1. Also corepressor for ERBB4. Inhibits E2F1 activity by stimulating E2F1-HDAC1 complex formation and inhibiting E2F1 acetylation. May serve as a partial backup to prevent E2F1-mediated apoptosis in the absence of RB1. Important regulator of CDKN1A/p21(CIP1). Has E3 SUMO-protein ligase activity toward itself via its PHD-type zinc finger. Also specifically sumoylates IRF7, thereby inhibiting its transactivation activity. Ubiquitinates p53/TP53 leading to its proteosomal degradation; the function is enhanced by MAGEC2 and MAGEA2, and possibly MAGEA3 and MAGEA6. Mediates the nuclear localization of KOX1, ZNF268 and ZNF300 transcription factors. In association with isoform 2 of ZFP90, is required for the transcriptional repressor activity of FOXP3 and the suppressive function of regulatory T-cells (Treg) (PubMed:23543754). Probably forms a corepressor complex required for activated KRAS-mediated promoter hypermethylation and transcriptional silencing of tumor suppressor genes (TSGs) or other tumor-related genes in colorectal cancer (CRC) cells (PubMed:24623306). Also required to maintain a transcriptionally repressive state of genes in undifferentiated embryonic stem cells (ESCs) (PubMed:24623306). Associates at promoter regions of tumor suppressor genes (TSGs) leading to their gene silencing (PubMed:24623306). The SETDB1-TRIM28-ZNF274 complex may play a role in recruiting ATRX to the 3'-exons of zinc-finger coding genes with atypical chromatin signatures to establish or maintain/protect H3K9me3 at these transcriptionally active regions (PubMed:27029610). Acts as a corepressor for ZFP568 .
Related Products / Services
Please note: All products are "FOR RESEARCH USE ONLY AND ARE NOT INTENDED FOR DIAGNOSTIC OR THERAPEUTIC USE"
